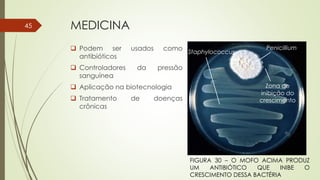
MEDICINA
Staphylococcus
Penicillium
Zona de
inibição do
crescimento
 Podem ser usados como
antibióticos
 Controladores da pressão
sanguínea
 Aplicação na biotecnologia
 Tratamento de doenças
crônicas
FIGURA 30 – O MOFO ACIMA PRODUZ
UM ANTIBIÓTICO QUE INIBE O
CRESCIMENTO DESSA BACTÉRIA
45

O documento explora a diversidade dos fungos, destacando sua importância ecológica, suas estruturas e modos de reprodução, além de detalhar suas relações com outros organismos, como plantas e animais. Os fungos desempenham papéis essenciais como decompositores, mutualistas e patógenos, influenciando os ciclos biológicos e sendo utilizados em diversas aplicações, desde agricultura até medicina. Também são discutidas suas origens evolutivas e a presença de diferentes grupos de fungos, como quitrídeos, zigomicetos, glomeromicetos, ascomicetos e basidiomicetos.